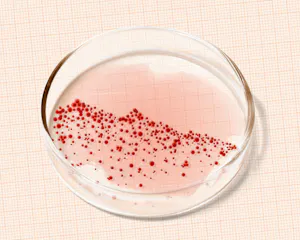
Beroerd beursjaar voor Nederlandse biotechbedrijven

Hoe Apple ons leven in vijftig jaar heeft veranderd
Apple bestaat vijftig jaar. Het iconische techbedrijf groeide uit van rebelse uitdager tot machtige vormgever van onze dagelijkse realiteit. ‘Mensen hebben geen idee hoe Apple onze manier van leven heeft beïnvloed.’